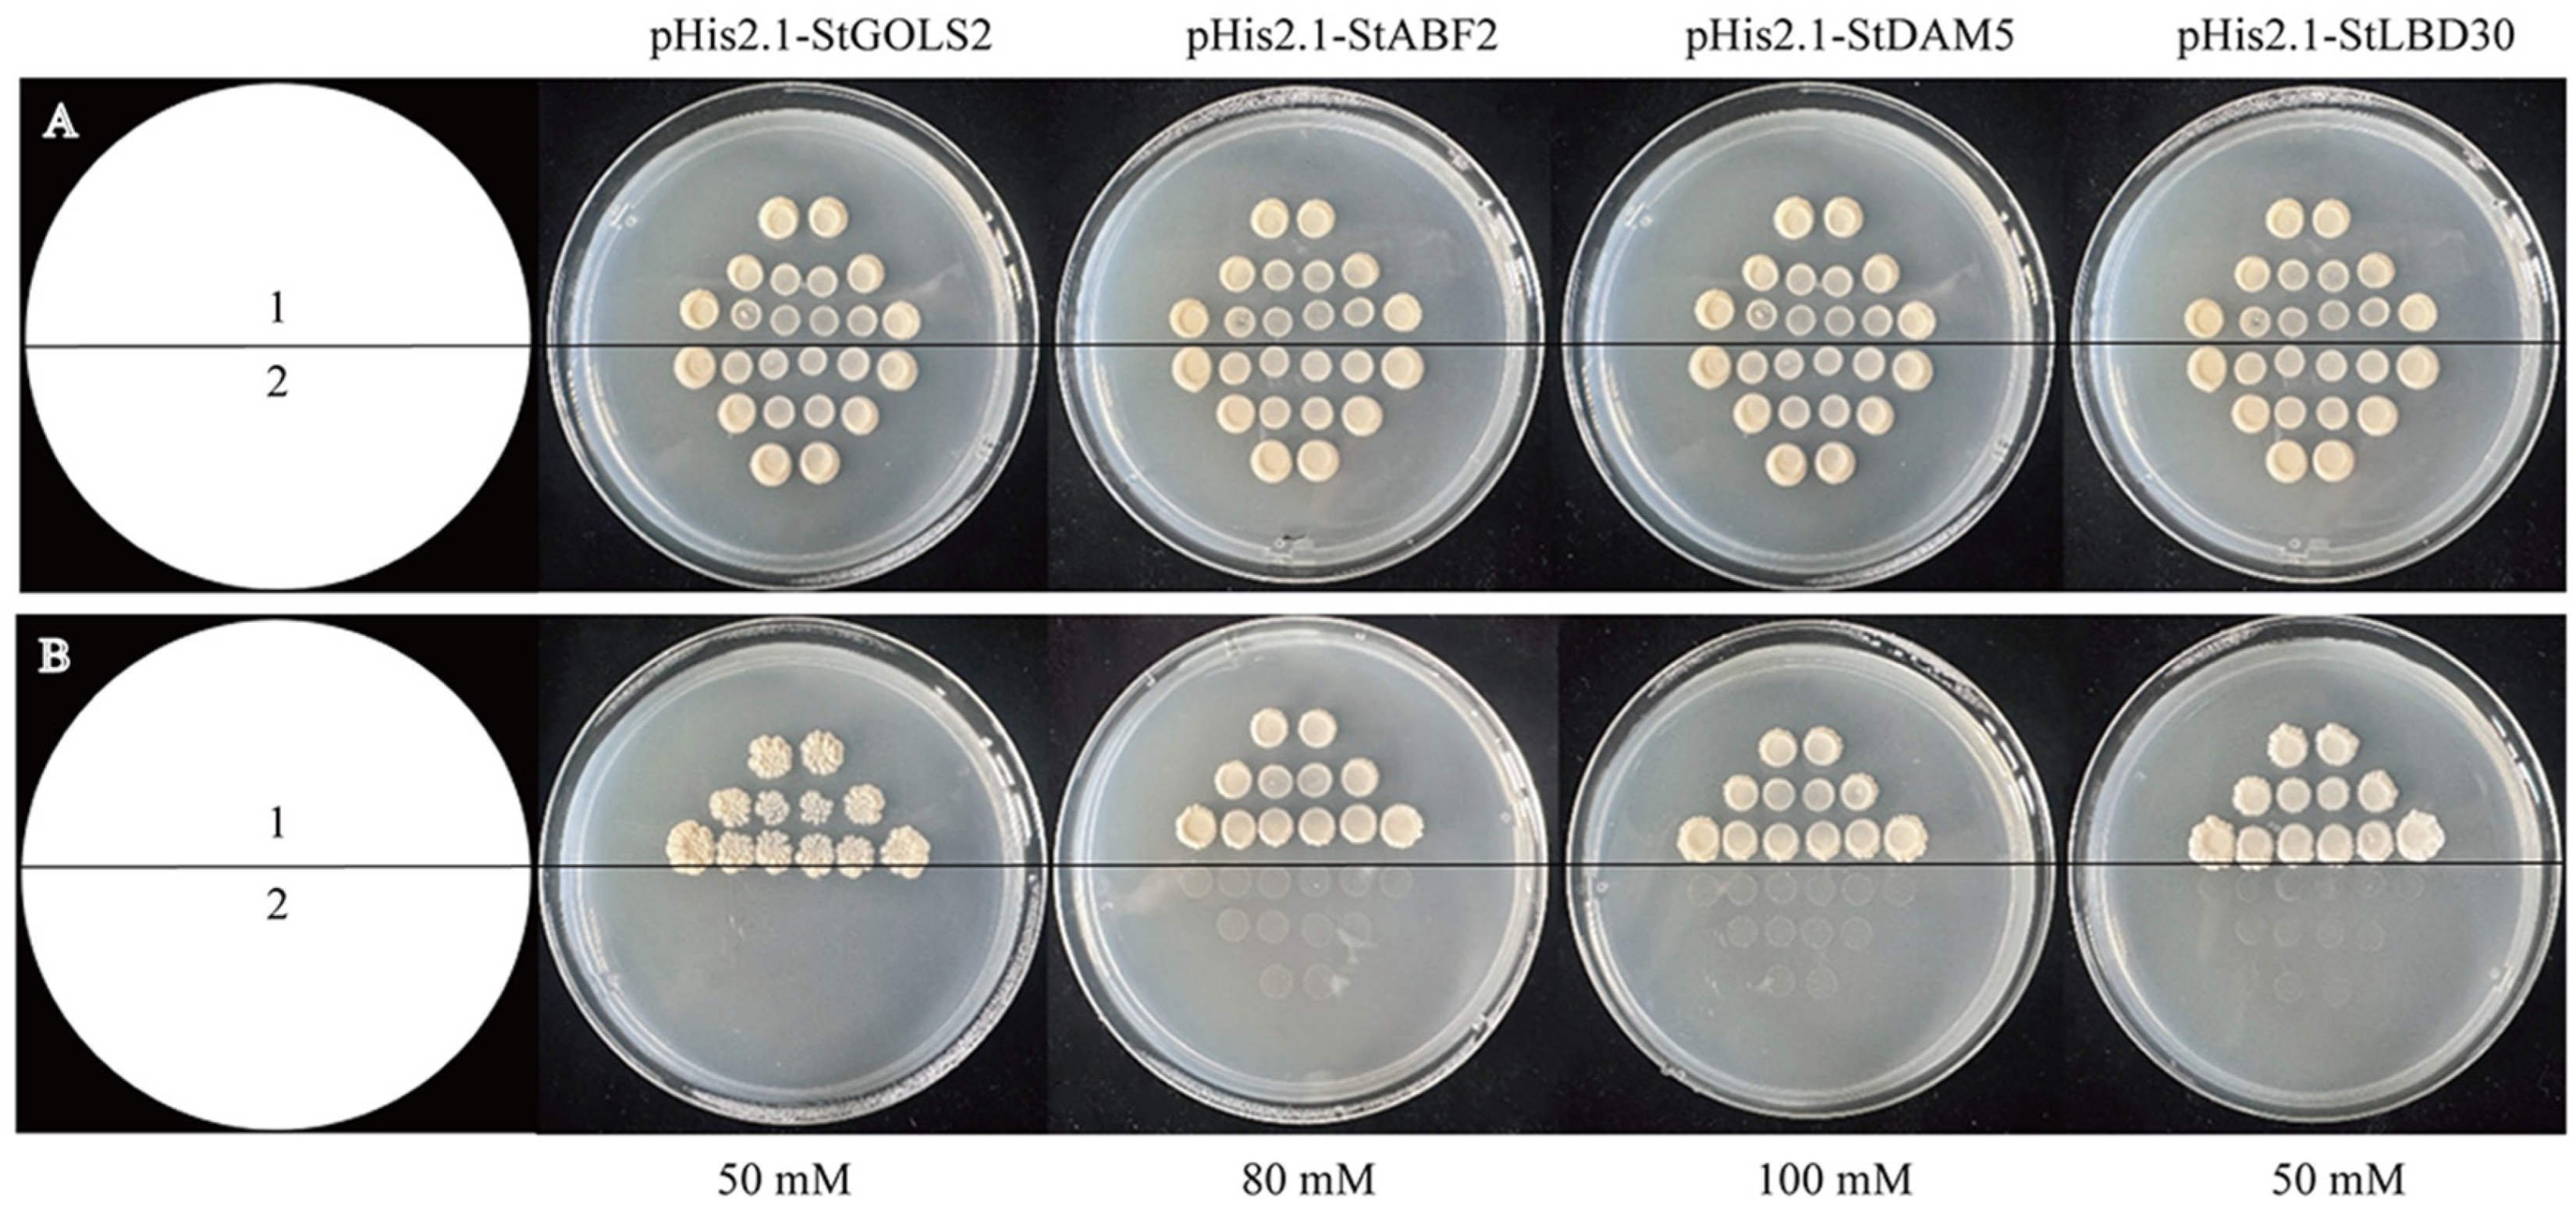
Ijms 25 10450 g002

Screening and Identification of Target Gene of StTCP7 Transcription Factor in Potato
Abstract
1. Introduction
2. Results
2.1. Analysis of Promoter Elements of Target Genes
2.2. Self-Activation Detection of Bait Vector
2.3. Yeast One Hybridization Verification
2.4. Verification by Double Luciferase Test
2.5. qRT-PCR Analysis
2.6. Bioinformatics Analysis of Target Gene StDAM5
2.7. Subcellular Localization of the Target Gene StDAM5
3. Discussion
4. Materials and Methods
4.1. Plant Materials and Growth Conditions
4.2. Analysis of Target Gene Promoter Elements of StTCP7 Transcription Factor
4.3. Construction of Yeast One Hybridization Vector
4.4. Self-Activation Detection of Bait Carrier
4.5. Yeast One Hybridization Test
4.6. Double Luciferase Test
4.7. qRT-PCR Analysis Method
4.8. Bioinformatics and Expression Analysis of Target Gene StDAM5
4.9. Subcellular Localization of Target Gene StDAM5
5. Conclusions
Supplementary Materials
Author Contributions
Funding
Institutional Review Board Statement
Informed Consent Statement
Data Availability Statement
Acknowledgments
Conflicts of Interest
References
- Lopez, A.; Arazuri, S.; Garcia, I.; Mangado, J.; Jaren, C. A review of the application of near-infrared spectroscopy for the analysis of potatoes. J. Agric. Food Chem. 2013, 61, 5413–5424. [Google Scholar] [CrossRef] [PubMed]
- Mikhaylichenko, O.; Bondarenko, V.; Harnett, D.; Schor, I.; Males, M.; Viales, R.; Furlong, E. The degree of enhancer or promoter activity is reflected by the levels and directionality of eRNA transcription. Genes Dev. 2018, 32, 42–57. [Google Scholar] [CrossRef] [PubMed]
- Cubas, P.; Lauter, N.; Doebley, J.; Coen, E. The TCP domain: A motif found in proteins regulating plant growth and development. Plant J. 1999, 18, 215–222. [Google Scholar] [CrossRef] [PubMed]
- Kosugi, S.; Ohashi, Y. DNA binding and dimerization specificity and potential targets for the TCP protein family. Plant J. 2002, 30, 337–348. [Google Scholar] [CrossRef]
- Tang, Y.; Gao, X.; Cui, Y. Research advances in the plant TCP transcription factors. Chin. Sci. Bull. 2022, 67, 3964–3975. [Google Scholar] [CrossRef]
- Passmore, S.; Maine, G.T.; Elble, R.; Christ, C. Saccharomyces cerevisiae protein involved in plasmid maintenance is necessary for mating of MATα cells. J. Mol. Biol. 1988, 204, 593–606. [Google Scholar] [CrossRef]
- Yanofsky, M.; Ma, H.; Bowman, J.; Drews, G.; Feldmann, K.; Meyerowitz, E. The protein encoded by the Arabidopsis homeotic gene agamous resembles transcription factors. Nat. Commun. 1990, 346, 35–39. [Google Scholar] [CrossRef]
- Schwarz-Sommer, Z.; Hue, I.; Huijser, P.; Flor, P.; Hansen, R.; Tetens, F.; Lonnig, W.; Saedler, H.; Sommer, H. Characterization of the Antirrhinum floral homeotic MADS-box gene deficiens: Evidence for DNA binding and autoregulation of its persistent expression throughout flower development. Embo. J. 1992, 11, 251–263. [Google Scholar] [CrossRef]
- Norman, C.; Runswick, M.; Pollock, R.; Treisman, R. Isolation and properties of cDNA clones encoding SRF, a transcription factor that binds to the c-fos serum response element. Cell 1988, 55, 989–1003. [Google Scholar] [CrossRef]
- Uberti-Manassero, N.; Leandro, E.; Ivana, L.; Abelardo, C.; Daniel, H. The class I protein AtTCP15 modulates plant development through a pathway that overlaps with the one affected by CIN-like TCP proteins. J. Exp. Bot. 2012, 63, 809–823. [Google Scholar] [CrossRef]
- Wang, S.; Sun, X.; Hoshino, Y.; Yu, Y.; Jia, B.; Sun, Z.; Sun, M.; Duan, X.; Zhu, Y. MicroRNA319 positively regulates cold tolerance by targeting OsPCF6 and OsTCP21 in rice (Oryza sativa L.). PLoS ONE. 2014, 9, e91357. [Google Scholar] [CrossRef] [PubMed]
- Dong, W.; Ren, W.; Wang, X.; Mao, Y.; He, Y. MicroRNA319 a regulates plant resistance to Sclerotinia stem rot. J. Exp. Bot. 2021, 72, 3540–3553. [Google Scholar] [CrossRef] [PubMed]
- Almeida, D.; Gregorio, G.; Oliveira, M.; Saibo, N. Five novel transcription factors as potential regulators of OsNHX1 gene expression in a salt tolerant rice genotype. Plant Mol. Biol. 2017, 93, 61–77. [Google Scholar] [CrossRef] [PubMed]
- Ding, S.; Cai, Z.; Du, H.; Wang, H. Genome-wide analysis of TCP family genes in Zea mays L. identified a role for ZmTCP42 in drought tolerance. Int. J. Mol. Sci. 2019, 20, 2762. [Google Scholar] [CrossRef]
- Liu, Y.; Jian-Ping, A.; Gao, N.; Wang, X.; Chen, X.; Wang, X.; Zhang, S.; You, C. MdTCP46 interacts with MdABI5 to negatively regulate ABA signalling and drought response in apple. Plant Cell Environ. 2022, 45, 3233–3248. [Google Scholar] [CrossRef]
- De Bodt, S.; Raes, J.; Van de Peer, Y.; Theissen, G. And then there were many: MADS goes genomic. Trends Plant Sci. 2003, 8, 475–483. [Google Scholar] [CrossRef]
- Guo, X.; Chen, G.; Cui, B.; Qiong, G.; Guo, J.; Li, A.; Zhang, L.; Hu, Z. Solanum lycopersicum agamous-like MADS-box protein AGL15-like gene, SlMBP11, confers salt stress tolerance. Mol. Breed. 2016, 36, 125. [Google Scholar] [CrossRef]
- Zhang, Z. Cloning and Functional Analysis of Drought Stress Induced Gene ZmMADS4 in Maize (Zea mays L.). Master’s Thesis, Chinese Academy of Agricultural Sciences, Beijing, China, 2007. [Google Scholar]
- Zhang, X.; Li, T.; Chen, H.; Tang, H.; Mu, Y.; Gou, L.; Lan, X.; Ma, J. The wheat (Triticum aestiveum L.) MADS-box transcription factor TaMADS32 plays a role in response to abiotic stresses. Biotechnol. Biotec. Eq. 2022, 36, 451–461. [Google Scholar] [CrossRef]
- Yang, F.; Xu, F.; Wang, X.; Liao, Y.; Chen, Q.; Meng, X. Characterization and functional analysis of a MADS-box transcription factor gene (GbMADS9) from Ginkgo biloba. Sci. Hortic. 2016, 212, 104–114. [Google Scholar] [CrossRef]
- Lei, D.; Su, Z.; Wu, Y. Cloning and expression analysis of a transcription factor SlTCP7 in tomato. Molecular Plant Breeding. 2019, 17, 1446–1453. [Google Scholar] [CrossRef]
- Zhao, Y. Cloning of StTCP7 Gene from Potato and Analysis of Its Drought Resistance and Salt Tolerance Function. Master’s Thesis, Gansu Agricultural University, Lanzhou, China, 2023. [Google Scholar] [CrossRef]
- Samad, A.; Sajad, M.; Nazaruddin, N.; Fauzi, I.A.; Murad, A.; Zainal, Z.; Ismail, I. MicroRNA and transcription factor: Key players in plant regulatory network. Front. Plant Sci. 2017, 8, 565. [Google Scholar] [CrossRef] [PubMed]
- Manna, M.; Thakur, T.; Chirom, O.; Mandlik, R.; Deshmukh, R.; Salvi, P. Transcription factors as key molecular target to strengthen the drought stress tolerance in plants. Physiol. Plant. 2021, 172, 847–868. [Google Scholar] [CrossRef] [PubMed]
- Zhang, M. Molecular Mechanism of OsWRKY63 Regulating Cold Tolerance in Rice (Oryza sativa L.). Ph.D. Thesis, Jilin University, Changchun, China, 2022. [Google Scholar]
- Wang, Y. Functional Identification of GhMYB4, GbTCP4 and GbTCP5 in Cotton Drought and Salt Stress. Ph.D. Thesis, Xinjiang Agricultural University, Urumqi, China, 2022. [Google Scholar] [CrossRef]
- Wang, Q. Molecular Mechanism of PpTCP20 Transcription Factor Regulating Bud Endodormancy Release in Peach. Ph.D. Thesis, Shandong Agricultural University, Tai’an, China, 2020. [Google Scholar] [CrossRef]
- Mukhopadhyay, P.; Tyagi, A. Erratum: OsTCP19 influences developmental and abiotic stress signaling by modulating ABI4-mediated pathways. Sci. Rep. 2015, 5, 9998. [Google Scholar] [CrossRef] [PubMed]
- Zang, P. Drought-resistance Functional Verification and Regulatory Factors Screening of VyP5CR Gene from Chinese wild Vitis yeshanensis. Master’s Thesis, Northwest Science of Agriculture and Forestry, Xianyang, China, 2022. [Google Scholar] [CrossRef]
- Ren, L.; Dong, J.; Yang, Y.; Haijiao, H. Cloning and expression analysis of BpTCP7 promoter from Betula platyphylla. J. Nanjing For. Univ. (Nat. Sci. Ed.) 2019, 43, 32–38. [Google Scholar]
- Verslues, P.; Yongsig, K.; Jiankang, Z. Altered ABA, proline and hydrogen peroxide in an Arabidopsis glutamate: Glyoxylate aminotransferase mutant. Plant Mol. Biol. 2007, 64, 205–217. [Google Scholar] [CrossRef]
- Nakashima, K.; Yamaguchi-Shinozaki, K. ABA signaling in stress-response and seed development. Plant Cell Rep. 2013, 32, 959–970. [Google Scholar] [CrossRef]
- Hussain, Q.; Asim, M.; Zhang, R.; Khan, R.; Farooq, S.; Wu, J. Transcription factors interact with ABA through gene expression and signaling pathways to mitigate drought and salinity stress. Biomolecules 2021, 11, 1159. [Google Scholar] [CrossRef]
- Asad, M.; Zakari, S.; Zhao, Q.; Zhou, L.; Ye, Y.; Cheng, F. Abiotic stresses intervene with ABA signaling to induce destructive metabolic pathways leading to death: Premature leaf senescence in plants. Int. J. Mol. Sci. 2019, 20, 256. [Google Scholar] [CrossRef]
- Wan, S.; Liang, B.; Yang, L.; Hu, W.; Kuang, L.; Song, J.; Xie, J.; Huang, Y.; Liu, D.; Liu, Y. The MADS-box family gene PtrANR1 encodes a transcription activator promoting root growth and enhancing plant tolerance to drought stress. Plant Cell Rep. 2023, 43, 16. [Google Scholar] [CrossRef]
- Zhao, P.; Miao, Z.; Zhang, J.; Chen, S.; Liu, Q.; Xiang, C. Arabidopsis MADS-box factor AGL16 negatively regulates drought resistance via stomatal density and stomatal movement. J. Exp. Bot. 2020, 71, 6092–6106. [Google Scholar] [CrossRef]
- Xue, Y.; Ma, L.; Wang, H.; Hao, P.; Cheng, S.; Su, Z.; Li, L.; Yu, S.; Wei, H. The MADS transcription factor GhFYF is involved in abiotic stress responses in upland cotton (Gossypium hirsutum L.). Gene 2022, 815, 146138. [Google Scholar] [CrossRef] [PubMed]
- Qi, X.; Liu, C.; Song, L.; Li, M. PaMADS7, a MADS-box transcription factor, regulates sweet cherry fruit ripening and softening. Plant Sci. 2020, 301, 110634. [Google Scholar] [CrossRef] [PubMed]
- Cheng, X.; Wang, H.; Wei, H.; Gu, L.; Hao, P.; Sun, H.; Wu, A.; Cheng, S.; Yu, S. The MADS transcription factor GhAP1.7 coordinates the flowering regulatory pathway in upland cotton (Gossypium hirsutum L.). Gene 2021, 769, 145235. [Google Scholar] [CrossRef]
- Cai, Y.; Wang, L.; Ogutu, C.; Yang, Q.; Luo, B.; Liao, L.; Zheng, B.; Zhang, R.; Han, Y. The MADS-box gene PpPI is a key regulator of the double-flower trait in peach. Physiol. Plant 2021, 173, 2119–2129. [Google Scholar] [CrossRef] [PubMed]
- Shen, C.; Chen, Y.; Liu, K.; Lu, H.; Chang, S.; Hsiao, Y.; Yang, F.; Zhu, G.; Zou, S.; Huang, L.; et al. Orchid B (sister) gene PeMADS28 displays conserved function in ovule integument development. Sci. Rep. 2021, 11, 1205. [Google Scholar] [CrossRef]
- Zhang, Y.; Wang, L. The WRKY transcription factor superfamily: Its origin in eukaryotes and expansion in plants. BMC Evol. Biol. 2005, 5, 1. [Google Scholar] [CrossRef]
- Wang, F. Identification of StERF109 Gene Function in Potato. Master’s Thesis, Gansu Agricultural University, Lanzhou, China, 2021. [Google Scholar] [CrossRef]
- Wang, X.; Wei, H.; Li, S.; Wang, K.; Zhao, L. Expression analysis of the StNF-YA8 gene associated with dormancy release in potato (Solanum tuberosum). J. Agric. Biotech. 2024, 32, 50–59. [Google Scholar] [CrossRef]
- Rao, X.; Huang, X.; Zhou, Z.; Lin, X. An improvement of the 2−ΔΔCT method for quantitative real-time polymerase chain reaction data analysis. Biostat. Bioinform. Biomath. 2013, 3, 71–85. [Google Scholar]
Binding motif;
ATG;
Selected truncation sequence.
Binding motif;
ATG;
Selected truncation sequence.

| Name | Sequence | Account | Function |
|---|---|---|---|
| ABRE | ACGTG | 3 | cis-acting element involved in the abscisic acid responsiveness |
| AE-box | AGAAACAA/AGAAACTT | 2 | part of a module for light response |
| ARE | AAACCA | 3 | cis-acting regulatory element essential for the anaerobic induction |
| CAAT-box | CAAAT/CAAT/CCAAT/CCCAATTT | 29 | common cis-acting element in promoter and enhancer regions |
| G-Box | CACGTT | 3 | cis-acting regulatory element involved in light responsiveness |
| MYB | TAACCA | 1 |
Disclaimer/Publisher’s Note: The statements, opinions and data contained in all publications are solely those of the individual author(s) and contributor(s) and not of MDPI and/or the editor(s). MDPI and/or the editor(s) disclaim responsibility for any injury to people or property resulting from any ideas, methods, instructions or products referred to in the content. |
© 2024 by the authors. Licensee MDPI, Basel, Switzerland. This article is an open access article distributed under the terms and conditions of the Creative Commons Attribution (CC BY) license (https://creativecommons.org/licenses/by/4.0/).
Share and Cite
Si, X.; Xu, W.; Fan, J.; Wang, K.; Zhang, N.; Si, H. Screening and Identification of Target Gene of StTCP7 Transcription Factor in Potato. Int. J. Mol. Sci. 2024, 25, 10450. https://doi.org/10.3390/ijms251910450
Si X, Xu W, Fan J, Wang K, Zhang N, Si H. Screening and Identification of Target Gene of StTCP7 Transcription Factor in Potato. International Journal of Molecular Sciences. 2024; 25(19):10450. https://doi.org/10.3390/ijms251910450
Chicago/Turabian StyleSi, Xingru, Wenjin Xu, Junliang Fan, Kaitong Wang, Ning Zhang, and Huaijun Si. 2024. "Screening and Identification of Target Gene of StTCP7 Transcription Factor in Potato" International Journal of Molecular Sciences 25, no. 19: 10450. https://doi.org/10.3390/ijms251910450
APA StyleSi, X., Xu, W., Fan, J., Wang, K., Zhang, N., & Si, H. (2024). Screening and Identification of Target Gene of StTCP7 Transcription Factor in Potato. International Journal of Molecular Sciences, 25(19), 10450. https://doi.org/10.3390/ijms251910450

